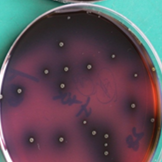

海博微信公众号
海博微信公众号
 海博天猫旗舰店
海博天猫旗舰店


 海博微信公众号
海博微信公众号
 海博天猫旗舰店
海博天猫旗舰店




一、试验原理
PALCAM琼脂培养基用于李斯特菌的选择性分离。培养基中的氯化锂、添加剂1和添加剂2主要抑制非李斯特菌的生长。37℃培养18-24h,单核增生李斯特氏菌可分解培养基中的七叶苷,生成的物质与柠檬酸铁铵中的铁离子作用生成一种黑色物质,从而使菌落周围培养基颜色变黑。
二、试验结果判断
在海博公司生产的PALCAM琼脂培养基上,单核增生李斯特菌的菌落特征非常典型,表现为:
1、菌落灰绿色,中心有凹陷;
2、菌落周围有一黑色环。(特征如下图)
三、注意事项
1 此培养基中含有多种添加剂,使用时,应先将基础培养基121℃高温灭菌15min,冷却至 50℃左右加入各种配套的添加剂,充分混匀后再倾入无菌平皿;
2 不能在培养基基础温度很高时加入添加剂,绝对禁止将添加剂和培养基基础一起灭菌;
3 使用添加剂时,应带手套小心操作,避免溅出,一旦沾染,应立即用酒精棉球擦拭干净;
4 使用该培养基,应在35-37℃培养足够24-48h再观察结果。
相关产品:
注:本文属海博生物原创,未经允许不得转载。
下一篇:KEA肉汤原理及现象



